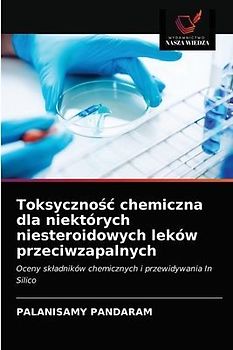
Toksyczno¿¿ chemiczna dla niektórych niesteroidowych leków przeciwzapalnych

Cannabinoids in Food Science

Quantum Chemical Studies of Weakly Coordinated Ionic Systems

Chemical Analysis for Schools & Colleges: A Lab Manual

Molecular and Materials Design

Spektroskopische und drogenfreie Eigenschaften einer neuen Sulfonamid-Verbindung

AlPNT as a new sensor

Plattner's Manual of Qualitative and Quantitative Analysis With the Blowpipe. From the Last German Edition, Reviesed and Enlarged by Professor Th. Richter ... Tr. by Henry B. Cornwall ... Assisted by John H. Caswell

Estructura y reactividad de algunas moléculas de fármacos antituberculosos

Conception computationnelle pour la formation de complexes de chrome (VI)

Computational design for the formation of Chromium (VI) complexes

Structure et réactivité de quelques molécules de médicaments antituberculeux
Toksyczno¿¿ chemiczna dla niektórych niesteroidowych leków przeciwzapalnych

Confiscation of aromatic compounds. Microwave synthesized electrolyte treated and Si/Al enhanced mesoporous zeolitic materials originated from sugar industry detritus

Computergestütztes Design für die Bildung von Chrom(VI)-Komplexen

High-Temperature Liquid Chromatography

Guide to a Course of Quantitative Chemical Analysis, Especially of Minerals and Furnace-products
Lieber Geld verdienen als ausgeben?
Verkauf Elektronik und Medien ganz einfach an uns
Versand immer kostenlos und versichert 100 % Löschung deiner Daten Erfahrung und Sicherheit seit 2004
Der Streichpreis bezieht sich auf die unverbindliche Preisempfehlung des Herstellers, den aktuellen durchschnittlichen Neupreis des Produktes bei idealo Deutschland, oder bei Büchern auf den festgelegten Preis für Neuware.














